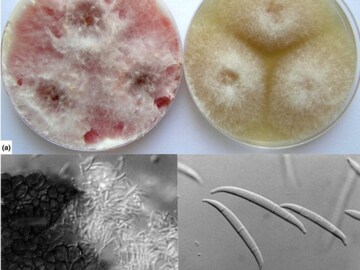
அமெரிக்காவிற்குள் கடத்தப்பட்ட வைரஸ் அமெரிக்காவிற்குள் கடத்தப்பட்ட வைரஸ்

Last Updated:
அமெரிக்காவில் சீன ஆய்வாளர்கள் 2 பேர் அபாயகரமான பூஞ்சையை கடத்தியதாக கைது செய்யப்பட்டுள்ளார்கள்.
கோதுமை, சோளம் உள்ளிட்ட பயிர்கள் மூலம் மனிதர்களுக்கு நோய்களைப் பரப்பும் அபாயகரமான பூஞ்சையை, அமெரிக்காவிற்குள் கடத்தியதாக சீன ஆய்வாளர்கள் 2 பேர் கைது செய்யப்பட்டனர்.
இது தொடர்பாக FBI இயக்குநர் காஷ் படேல் வெளியிட்டுள்ள செய்திக் குறிப்பில், அமெரிக்காவின் மிச்சிகன் பல்கலைக்கழகத்தில் பணியாற்றிய சீனாவைச் சேர்ந்த யூங்கிங் ஜியான் (YUNGING JIAN) என்ற இளம்பெண் அபாயகரமான கிருமியைக் கடத்திய புகாரில் கைது செய்யப்பட்டதாகக் கூறப்பட்டுள்ளது.
ஃப்யூசேரியம் கிராமிநியரம் (Fusarium graminearum) என்ற அபாயகரமான பூஞ்சை மூலம் கோதுமை, சோளம் உள்ளிட்ட பயிர்களுக்கு ஹெட் பிளைட் (Head blight) என்னும் நோயைப் பரப்ப அவர் திட்டமிட்டதாக காஷ் படேல் குறிப்பிட்டுள்ளார்.
இதன் மூலம், மனிதர்கள் மற்றும் கால்நடைகளுக்கு ஆபத்து நேரிடுவதுடன், உணவுச் சங்கிலி பாதிக்கப்பட்டு, உலகம் முழுவதும் ஆண்டுதோறும் பில்லியன் டாலர் அளவிற்குப் பொருளாதார இழப்பு ஏற்பட்டிருக்கும் என்றும் காஷ் படேல் தெரிவித்துள்ளார்.
கைது செய்யப்பட்ட இளம்பெண்ணின் காதலன், சீனாவில் உள்ள பல்கலைக்கழகத்தில் பணியாற்றி வருவதாகவும், டெட்ராயிட் விமானநிலையம் மூலம், அபாயகரமான பூஞ்சையைக் கடத்தத் திட்டம் தீட்டியதாகவும் FBI இயக்குநர் தனது செய்திக் குறிப்பில் குறிப்பிட்டுள்ளார்.
மேலும், சீன கம்யூனிஸ்ட் கட்சியின் நிதி உதவி மூலம், இந்தச் சதித் திட்டம் தீட்டப்பட்டதற்கான ஆதாரங்கள் கிடைத்திருப்பதாகவும் காஷ் படேல் குற்றம் சாட்டியுள்ளார்.
June 04, 2025 1:26 PM IST